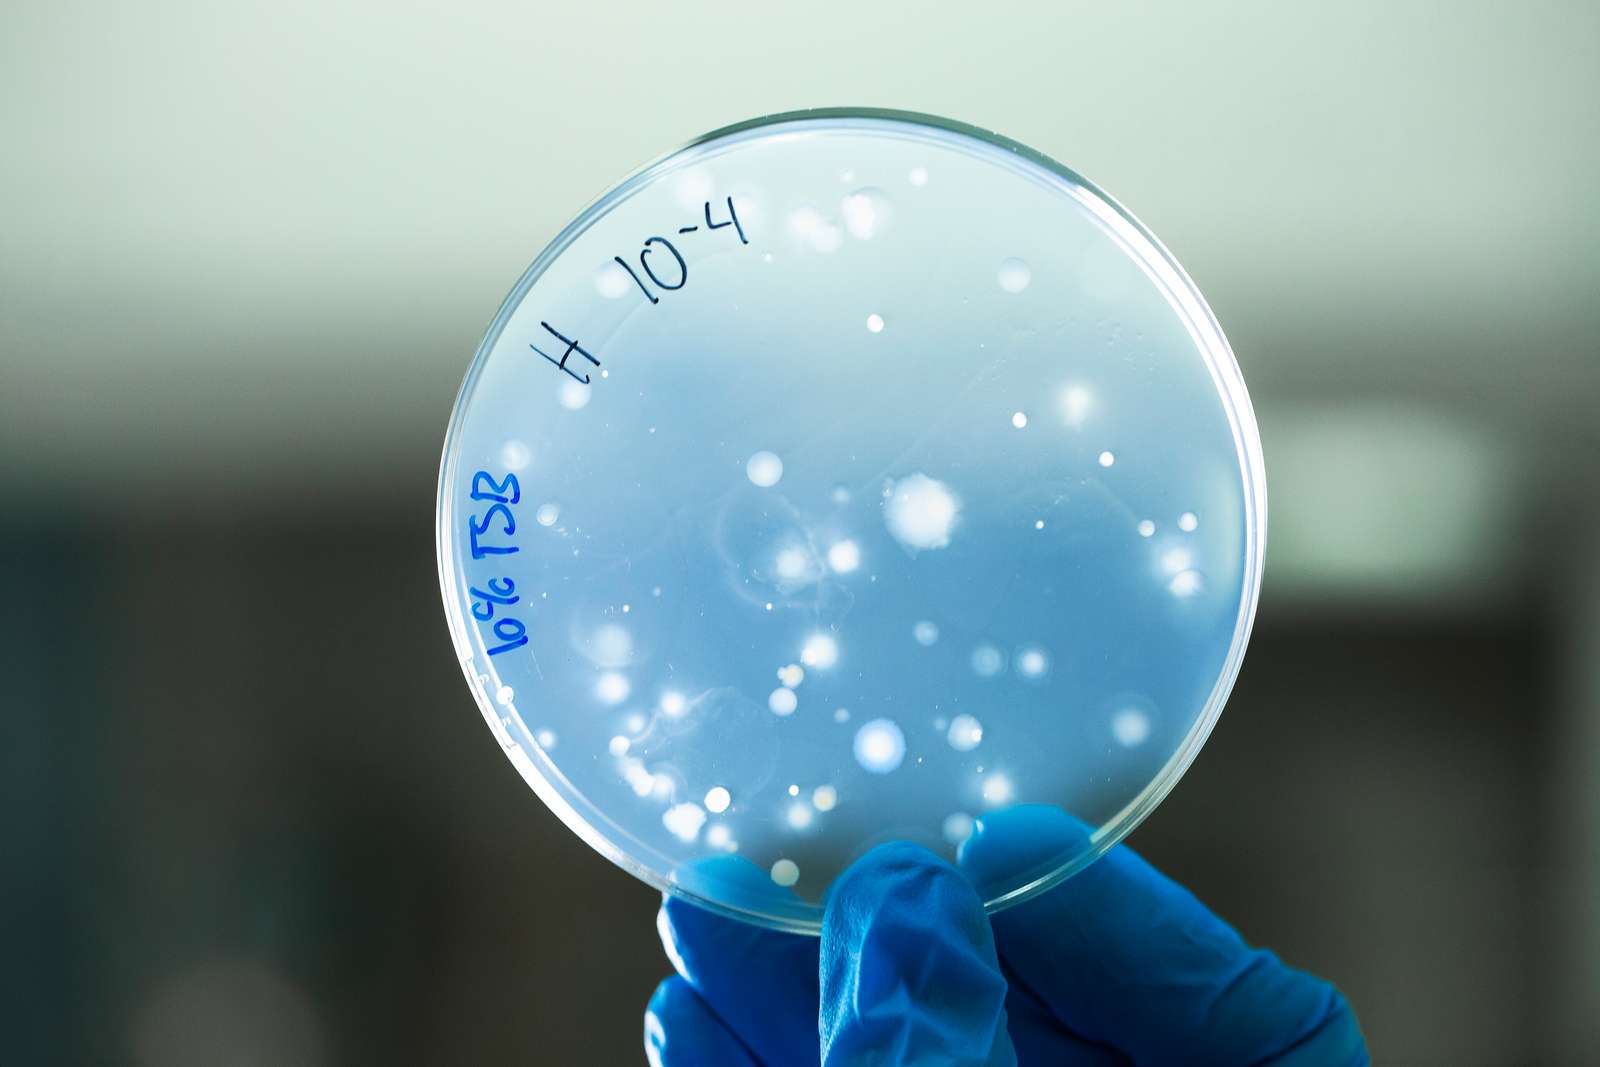
En plade med bakterier holdt af en h�nd med handsker p�

Rengøring og desinfektion af medicinsk udstyr
Rengøring og desinfektion af genanvendeligt medicinsk udstyr
Rengøring og desinfektion af medicinsk udstyr er vigtigt for både patientsikkerhed, produktkvalitet og dokumentation.
Vi tilbyder faglig sparring om håndtering af medicinsk udstyr samt validering og dokumentation af rengørings- og desinfektionsmetoder.
Hvornår er rengøring og desinfektion af medicinsk udstyr relevant?
Rengøring og desinfektion af medicinsk udstyr er relevant, når udstyr skal kunne bruges sikkert, og når der er behov for dokumenterede processer for rengøring, desinfektion og hygiejne.
Det gælder blandt andet ved udvikling af nye produkter, ændringer i materialer eller design, dokumentationskrav og vurdering af hygiejnerisici.
Hvis procedurer for rengøring af medicinsk udstyr og desinfektion af medicinsk udstyr ikke er tilstrækkeligt beskrevet og dokumenteret, kan det påvirke både regulatoriske processer og den nødvendige dokumentation.
Hvad kan Teknologisk Institut hjælpe jer med?
Teknologisk Institut hjælper med faglig sparring og afklaring om rengøring og desinfektion af medicinsk udstyr.
- Afklare problemstillinger inden for rengøring og desinfektion af medicinsk udstyr
- Bidrage med fagligt grundlag for dokumentation
- Rådgivning om optimering af rengørings- og desinfektionsprocesser
- Validering af rengørings- og desinfektionsmetoder i henhold til nationale og internationale standarder
- Sparring om krav til produktgodkendelse og myndighedsdokumentation
- Analyse af effekten på materialer ved gentagen re-processering samt sikring af biokompatibilitet
- Skræddersyede tests baseret på anerkendte standarder
En struktureret proces sikrer kvalitet og dokumentation
Teknologisk Institut udvikler skræddersyede løsninger baseret på jeres specifikke behov og produkttyper. Tests følger aktuelle standarder og guidelines, så dokumentationen er valid i forhold til krav fra myndigheder og kunder.
Fra kickoff til færdig rapport guider vi jer gennem hele forløbet. Vi kortlægger jeres behov, udarbejder en skræddersyet testprotokol og udfører kemiske og mikrobiologiske analyser i akkrediterede laboratorier. I får løbende opdateringer, og vi samarbejder om eventuelle optimeringer, indtil dokumentationen er klar.
Hele processen tager typisk 8-10 uger fra første kontakt til færdig rapport. Vores strukturerede tilgang sikrer, at I hurtigt får den dokumentation, der skal til for at komme videre mod produktgodkendelse.
Mange virksomheder oplever, at dokumentationskrav til re-processering kan være en barriere for produktgodkendelse. Men når vi sammen finder den rigtige tilgang – gennem skræddersyede tests og analyser - bliver dokumentationen et aktiv i stedet for en udfordring." - Helle Stendahl Andersen, forretningsleder, Teknologisk institut.
Kemiske og mikrobiologiske analyser i akkrediterede laboratorier
Teknologisk Institut benytter relevante kemiske og mikrobiologiske analysemetoder for at dokumentere effektiviteten af rengørings- og desinfektionsmetoder. Instituttets akkrediterede laboratorier er udstyret til at udføre omfattende tests, der lever op til myndighedskrav og internationale standarder.
De kemiske og mikrobiologiske analyser er med til at dokumentere, at rengøring fjerner smuds som f.eks. blod, og at desinfektionen fjerner relevante mikroorganismer i tilstrækkelig grad, så resultaterne er pålidelige og reproducerbare.
Vi tester også effekten af gentagen re-processering på materialerne. Hvad sker der med plastik, metal eller gummi, når det rengøres og desinficeres 50, 100 eller 200 gange? Kan materialerne stadig rengøres og desinficeres ligeså effektivt? Er der risiko for nedbrydning eller frigivelse af stoffer? Og hvad betyder det for biokompatibiliteten?
Denne type end-of-life test er afgørende for at kunne angive, hvor mange gange det er sikkert at genbruge udstyret. Det giver både virksomheden og dens kunder tryghed og sikrer, at produktet lever op til kravene gennem hele dets levetid.

Case: Dansk virksomhed sikrede godkendelse af desinfektionsmetode fra FDA
En dansk virksomhed skulle hjælpe en amerikansk producent med at forbedre deres teknologi til desinfektion af udstyr til søvnapnø. Den amerikanske producent havde problemer med at reproducere deres laboratorieresultater ift. effekten af deres desinfektionsprocedure. Det var resultater, som var afgørende for at opnå FDA-godkendelse.
Teknologisk Institut testede teknologien sammen med den danske virksomhed i instituttets akkrediterede laboratorier. Gennem løbende forbedring af teknologien og tæt sparring med både den amerikanske producent og det amerikanske laboratorium, der skulle udføre de endelige tests, arbejdede Teknologisk Institut systematisk med at optimere desinfektionsmetoden.
Det lykkedes at udvikle en robust teknologi med reproducerbare resultater, så den kunne opfylde de gældende FDA-krav. Projektet viser, hvordan systematisk testning og optimering kan være afgørende for at opnå myndighedsgodkendelser og sikre adgang til vigtige markeder.
Opnå produktgodkendelse og adgang til markedet
Med valideret dokumentation for rengørings- og desinfektionsmetoder kan virksomheder opnå produktgodkendelse og leve op til myndighedskrav. Med tests fra Teknologisk Institut får I præcis den dokumentation, myndighederne kræver. I vil kunne fremvise rapporter fra et akkrediteret laboratorium, der viser, at metoderne virker. Det skaber tillid, gør det lettere at sælge produktet og styrker jeres konkurrenceposition.
Ofte stillede spørgsmål om test af rengøringsmetoder
Hvorfor skal virksomheder teste deres rengørings- og desinfektionsmetoder?
Virksomheder skal, overfor myndigheder og kunder, kunne dokumentere, at genanvendeligt medicinsk udstyr kan rengøres og desinficeres effektivt mellem hver anvendelse. Uden denne dokumentation kan virksomheder ikke opnå produktgodkendelse eller sælge udstyr til deres kunder.
Hvad er forskellen på rengøring og desinfektion af medicinsk udstyr?
Rengøring fjerner snavs og rester fra medicinsk udstyr, mens desinfektion reducerer mængden af mikroorganismer til et acceptabelt niveau. Begge dele kan være vigtige for sikker anvendelse og dokumentation.
Hvilke standarder skal tests følge?
Det afhænger af produktet, og hvor det skal sælges. Både nationale og internationale guidelines (f.eks. AAMI TIR12, ANSI/AAMI ST98) samt standarder (f.eks. ISO 17764, ISO 15885) vil være relevante. Teknologisk Institut rådgiver om, hvilke standarder der gælder for det specifikke produkt.
Hvor lang tid tager en validering af rengøringsmetoder?
En typisk validering tager minimum 8-10 uger fra første møde til færdig rapport. Dette inkluderer tid til at forstå virksomhedens behov, udarbejde protokol, udføre tests, analysere resultater og skrive rapport. Komplekse projekter kan tage længere tid, mens enkle valideringer kan gå hurtigere.
Hvad koster det at teste rengørings- og desinfektionsmetoder?
Prisen afhænger af, hvor omfattende testene skal være. Skal Teknologisk Institut teste én eller flere rengøringsmetoder? Hvor mange mikroorganismer skal inkluderes? Skal Instituttet teste effekten af gentagen re-processering? Kontakt Teknologisk Institut for et uforpligtende tilbud baseret på jeres specifikke behov.
Kan Teknologisk Institut hjælpe, hvis en virksomheds nuværende metode ikke virker godt nok?
Ja, det er en central del af vores service. Hvis testene viser, at en metode ikke er effektiv nok, hjælper vi med at identificere problemet og finde løsninger. Det kan være valg af bedre desinfektionsmidler, justering af tid eller temperatur, eller ændringer i proceduren.
Hvilke typer medicinsk udstyr kan Teknologisk Institut teste?
Teknologisk Institut kan teste de fleste typer genanvendeligt medicinsk udstyr. Vores ekspertise er særlig relevant for udstyr, der kræver en manuel rengøring eller desinfektion, f.eks. patientmonitorer, ultralydsscannere, slanger til udstyr og diverse instrumenter. Udstyret kan være lavet af metal, plastik, gummi eller kombinationer af materialer.
Er Teknologisk Instituts laboratorier akkrediterede?
Ja, Teknologisk Instituts laboratorier er akkrediterede. Det betyder, at Instituttets testmetoder og resultater lever op til internationale kvalitetsstandarder. Dette er vigtigt for, at dokumentationen bliver anerkendt af myndigheder og kunder.
Hvad er forskellen på rengøring og desinfektion?
Rengøring fjerner synligt snavs, organisk materiale og de fleste mikroorganismer fra overfladen. Desinfektion dræber eller inaktiverer de resterende mikroorganismer på et niveau, der gør udstyret sikkert at bruge. Begge processer er vigtige, og Teknologisk Institut kan teste effektiviteten af både rengøring og desinfektion.
Skal virksomheder teste effekten af gentagen re-processering?
Ja, hvis udstyret skal genbruges mange gange. Gentagen rengøring og desinfektion kan påvirke materialernes egenskaber og biokompatibilitet. Ved at teste dette kan I angive, hvor mange gange det er sikkert at bruge udstyret - en vigtig information for brugerne.
Kan Teknologisk Institut hjælpe med desinfektion af medicinsk udstyr?
Teknologisk Institut hjælper virksomheder med faglig sparring, vurdering og testrelateret støtte inden for rengøring og desinfektion af medicinsk udstyr, når der er behov for dokumentation eller afklaring.
Hvordan kan virksomheder bruge dokumentationen fra Teknologisk Instituts tests?
Dokumentationen kan bruges til myndighedsansøgninger, som del af virksomhedens tekniske dossier for CE-mærkning eller FDA-godkendelse, i kommunikation med hospitaler og distributører, og i brugsanvisninger. Rapporten er udformet, så den kan bruges direkte i disse sammenhænge.
Kan Teknologisk Institut hjælpe med FDA-godkendelse?
Teknologisk Institut kan udføre tests, der følger relevante standarder og kan bruges som dokumentation i en FDA-ansøgning. Instituttet har erfaring med at hjælpe virksomheder med at forberede dokumentation til både FDA og andre internationale myndigheder. Teknologisk Institut rådgiver også om, hvilke krav der gælder for jeres specifikke produkt.
Hvad sker der, hvis konkurrenter ikke har denne dokumentation?
Det giver jer en konkurrencefordel. Hospitaler og distributører foretrækker produkter med solid dokumentation for patientsikkerhed. Hvis konkurrenter ikke kan dokumentere effektive rengørings- og/eller desinfektionsmetoder, er der større sandsynlighed for, at kunder vælger jeres produkt.
Kontakt Teknologisk Institut i dag for en uforpligtende samtale om, hvordan Instituttet kan hjælpe jer med at validere og dokumentere rengørings- og desinfektionsmetoder.
